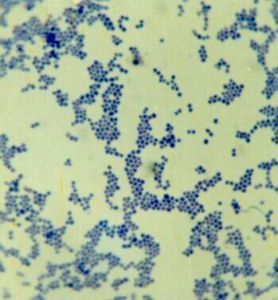
（圖）外科感染

外科感染膿腫
外科感染膿腫外科感染一般是指需要手術治療的感染性疾病和發生在創傷或手術後的的感染,在外科領域中最常見,約占所有外科疾病的1/3~1/2。常分為特異性和非特異性感染。其病原菌構成複雜,治療困難。
特點
1、大部分由幾種細菌引起,一部分即使開始時是單種細菌引起,但在病程中,常發展為幾種細菌的混合感染。
2、多數有明顯突出的局部症狀。
3、病變常比較集中在某個局部,發展後常引起化膿、壞死等,使組織遭到破壞,癒合後形成瘢痕組織,並影響功能。
分類
 破傷風表現
破傷風表現一、按病菌種類和病變性質歸類
1、非特異性感染又稱化膿性感染或一般感染,如癤、癰、丹毒、急性乳腺炎、急性闌尾炎等。常見致病菌有葡萄球菌、鏈球菌、大腸桿菌等。其特點是:同一種致病菌可以引起幾種不同的化膿性感染,如金黃色葡萄球菌能引起癤、癰、膿腫、傷口感染等;而不同的致病菌又可引起同一種疾病,如金黃色葡萄球菌、鏈球菌和大腸桿菌都能引起急性蜂窩織炎、軟組織膿腫、傷口感染等。有化膿性炎症的共同牲特徵,即紅、腫、熱、痛和功能障礙。防治上也有共同性。
2、特異性感染:如結核病、破傷風、氣性壞疽等。它們的致病菌、病程演變和防治方法,都與非特異性感染不同。
二、按照病程來分
1、急性感染:病變進展快明確,一般3周內非特異性感染分類多屬此類;
2、慢性感染:病變持續2個月素質以上;
3、亞急性感染:介於急性與慢性之間,由急性感染遷延而來,亦可其他由於病毒毒力弱但耐藥或抵抗力差所致。
三、其他分類:按感染的發生情況來分,可分為原發感染、繼發感染、混合感染、二重感染、條件性感染和醫院內感染等。條件性感染又稱機會感染,指平常為非致病或致病力低的病原菌,由於數量多和毒性增大,或人體抵抗力下降,乘機侵入而引起的感染。醫院內感染一般系指在醫院內因致病微生物侵入人體所引起的感染,通常是指在醫院內發生的創傷和燒傷感染,以及呼吸系統和泌尿系統的感染。醫院內感染的主要病菌是條件性病原菌。
病因

鏈球菌鏡下觀
外科感染是由致病微生物侵入體所引起,但人體的抵抗力與感染的發生有十分密切的關係。引起外科感染的常見化膿性致病菌有葡萄球菌、鏈球菌、大腸桿菌、綠膿桿菌和變形桿菌。由於抗生素的廣泛套用,一般的化膿性致病菌在外科感染中所占的比例和重要性有了改變。耐藥性金黃色葡萄感染雖然仍屬嚴重問題,但由革蘭氏染色陰性桿菌引起的感染更成為另一個嚴重問題。例如,原來的非致病或致病力低的某些革蘭氏染色陰性桿菌,如克雷伯菌、腸桿菌和少雷菌等因對一般的抗生素具有耐藥性,而逐漸變為重要的致病菌。還發現了厭氧菌如擬桿菌和梭形桿菌等與外科感染的關係。真菌感染已成為一種重要的、繼發於大量抗生素治療後的嚴重感染。接受複雜的大手術、器械檢查和插管、抗癌療法、放射療法、免疫抑制劑等的病人,由於接觸細菌的機會增多或抵抗力的削弱,也往往容易發生感染。也有一些醫務人員過分依賴抗菌藥物,忽視無菌操作或違反外科原則,也可引起一些本可避免的外科感染。
化膿性致病菌
金黃色葡萄球菌鏡下觀
金黃色葡萄球菌鏡下觀1、葡萄球菌:革蘭氏染色陽性。常存在於人的鼻、咽部黏膜和皮膚及其附屬的腺體。金黃色葡萄球菌的致病力甚強,主要產生溶血素、殺白細胞素和血漿凝固酶等,造成許多種感染、如癤、癰、膿腫、急性骨髓炎、傷口感染等。表皮葡萄球菌也能引起化膿性感染,特別是人造瓣膜、人造血管等換置術後,但致病力較弱。金黃色葡萄球菌感染的特點是局限性組織壞死,膿液稠厚、黃色、不臭。也能引起全身性感染,由於局限化的特性,常伴有轉移性膿腫。
2、鏈球菌:革蘭氏染色陽性。存在於口、鼻、咽和腸腔內。鏈球菌的種類很多,溶血性鏈球菌、綠色鏈球菌和糞鏈球菌(腸球菌)是三種常見的致病菌。一些厭氧鏈球菌和微量嗜氧鏈球菌也能致病。溶血性鏈球菌能產生溶血素和多種酶,如透明質酸酶、鏈激酶等,能溶解細胞間質的透明質酸、纖維蛋白和其他蛋白質,破壞纖維所形成的膿腫壁,使感染容易擴散而缺乏局限化的傾向。膿液的特點是比較稀薄,淡紅色,量較多。典型的感染是急性蜂窩織炎、丹毒、淋巴管炎等。也易引起敗血症,但一般不並發轉移性膿腫。綠色鏈球菌是一些膽道感染和亞急性心內膜炎的致病菌。糞鏈球菌則是腸道和闌尾穿孔引起急性腹膜炎的混合致病菌之一,也常引起泌尿道的感染。
3、大腸桿菌:革蘭氏染色陰性。大量存在於腸道內,每克糞內約有108個大腸桿菌。對維生素K的合成有重要作用。它的單獨致病力並不大。純大腸桿菌感染產生的膿液並無臭味,但因常和其他致病菌一起造成混合感染,如闌尾炎膿腫、急性膽囊炎等,產生的膿液稠厚,有惡臭或糞臭。
4、綠膿桿菌:革蘭氏染色陰性。常存在於腸道內和皮膚上。它對大多數抗菌藥物不敏感,故成為繼發感染的重要致病菌,特別是大面積燒傷的創面感染。有時能引起嚴重的敗血症。膿液的特點是淡綠色,有特殊的甜腥臭。
5、變型桿菌:革蘭氏染色陰性。存在於腸道和前尿道,為尿路感染、急性腹膜炎和大機種燒傷感染的致病菌之一。變型桿菌對大多數抗菌藥物有耐藥性,故在抗菌藥物治療後,原來的混合感染可以變為單純的變型桿菌感染,膿液具有特殊的亞臭。
6、克雷伯菌、腸桿菌、沙雷菌:革蘭氏染色陰性。存在於腸道內,常為醫院內感染的致病菌。往往和葡萄球菌、大腸桿菌或綠膿桿菌等一起造成混合感染,甚至形成敗血症。
7、擬桿菌:革蘭氏染色陰性的專性厭氧菌。存在於口腔、胃腸道和外生殖道,而以結腸內的數量最多,每克糞中約有1010個。它闌尾穿也所至的腹膜炎和胃腸道手術後感染的致病菌,並常和其他需氧菌和厭氧菌一起形成混合感染。它還可引起江表感染、深部膿腫、化膿性血栓性靜脈炎和敗血症等。膿液的特點是有惡臭,塗片可見到革蘭氏染色陰性的桿菌,但普通培養無細菌生長。
發病機制
 吞噬細胞鏡下觀
吞噬細胞鏡下觀1、局限性炎症反應 外科病人發生感染的部位可以是傷口、腹腔、肺部或人體任何部位微生物侵入組織並增殖,導致炎症反應的局部激活而形成臨床感染。病菌增殖。產生多種酶現毒素,可以激活凝血、補體、激肽系統以及血小板和巨噬細胞等,導致炎症介質諸如補體活化成分、緩激肽、腫瘤壞死因子(TNF-a)、白介素-1、血小板活化因子(PAF)、血栓素(TxA )等的分成,並引發相應的效應症狀,出現炎症的特徵性表現:紅、腫、熱、痛等。炎症介質可引起血管通透性增加及血管擴張,使得病變區域的血流增加。炎症反應產生的趨化因子吸引吞噬細胞進入感染部位。白細胞與血管內皮細胞以粘附分子結合而附壁,內皮細胞收縮使血管內皮間隙增大,有利於吞噬的移行,促使吞噬細胞進入感染區域以清除感染病原菌。中性粒細胞主要發揮吞噬作用,單核-巨噬細胞通過釋放促炎細胞因子協助炎症及吞噬過程。局部炎症反應的作用是使入侵的病原微生物局限化並最終被清除。
2、全身性炎症反應 侵襲性感染引起的全身性炎症反應與局部感染的徑路一樣,只是炎症反應的激活更為普遍,而且缺乏局部反應中明確的定向病灶。病菌及其產物逃脫局部防禦進入循環系統,導致血管內補體及凝血因子的激活。肥大細胞被全身激活所釋放的組胺現5-HT導致血管擴張及通透性增高。局部炎症嚴重時,可以釋放出大量TNF等促炎信號,使得循環中的巨噬細胞、中性粒細胞被激活,而且遠隔部位的巨噬細胞,如肺泡巨噬細胞、肝內枯否細胞亦被激活,引起播散性炎症細胞活化。全身水平上的炎症啟動,導致全身血管擴張、血流增加(高血流動力學狀態)以及全身水腫。炎症反應生成的趨化因子促使白細胞/內皮細胞相互反應及移行。全身促炎細胞因子連鎖反應,刺激中性粒細胞釋放溶酶體酶,並通過呼吸爆發生成氧自由基,目的在於殺死吞噬的細菌及分解壞死組織,但也可引起微血管內皮及血管周圍部位的損傷。微循環的炎症性損傷可引起血聚及血管收縮,最終導致微循環阻斷及組織破壞。壞死組織的形成又可引發局灶性炎症反應,並擴展到全身,如此形成惡性循環。全身炎症反應介導的組織特異性破壞是多器官功能障礙發生髮展的直接機制。
3、炎症介質如活化的補體、白三烯、血栓素、TNF-a、IL-1等,在不同時序有不同程度的升高。炎症介質生成量在。持續時間長則病性嚴重,預後差。促炎介質一般均具有激活炎症細胞,收縮內皮細胞,增加血管通透性,收縮血管,以及引發炎症連鎖反應的作用。參與SIRS的主要促炎介質有:
(1)細胞因子:TNF-a、IL-1、IL-8是重要的促炎細胞因子。TNF能活化內皮細胞,激活中性粒細胞、促進其邊聚及跨內皮細胞游出,刺激單核-巨噬細胞生成細胞因子。在啟動宿主應答反應、誘導急性炎症中TNF-a起到關鍵作用。IL-1主要激活巨噬細胞和內皮細胞,而IL-8是中性粒細胞的趨化因子,可促進炎症反應。
(2)花生四烯酸代謝物:包括前列環素、血栓素、白三烯等。前列環素由巨噬細胞、內皮細胞生成,可使血管擴張。血管壁通透性增高。血栓素使血小板聚集、微血管收縮、促使微血栓形成。花生四烯酸以脂氧化酶作用生成白三烯,可激活白細胞、收縮平滑肌;其中LTB 有很強的中性粒細胞趨化作用。血小板活化因子PAF可激活血小板,釋放組胺、5-HT等,是很強的促炎介質。
(3)其它:組織損傷後可激活補體、凝血因子、激肽與纖溶系統。補體激洛是扣傷後的早期改變,SIRS病人血漿中常有C3a、C5a等活化補體片段。除了促使肥大細胞釋放組胺外,C3a、C5a有很強的趨化作用。凝血因子XIIa在激活是,可分解激肽,後者具有活化白細胞、擴張血管及增加血管通透性的作用。
4、炎症反應的調控與失控 炎症是重要的防禦反應,但對外界刺激反應過度可對自身機體造成損害,炎症受到機體抗炎機制的控制。炎症細胞的激活有著明顯的自限性,如內毒素刺激使巨噬細胞的TNF-a表達迅速增加,但持續甚短。炎症細胞活化後又迅速失活,提示在細胞水平上有負反饋自我調節作用。炎症細胞生成的某些介質,具有抗炎作用,如IL-10、IL-4能抑制淋巴細胞。巨噬細胞生成細胞因子;可溶性TNF受體與血中TNF結合可以阻斷TNF的作用。機體分泌的糖皮質激素有很強的抗炎作用,能抑制包括細胞因子、粘附分子、花生四烯酸代謝物等從多炎症介質的生成,可以視為最重要的抗炎激素。上述作用均具有抗炎症效應。促炎效應與抗炎症效應兩者之間可以發揮協調、抑制或是相互拮抗的作用。在促炎反應占主導時表現為SIRS,而當抗炎反應占主導時表現為免疫抑制,即所謂代償性抗炎症反應綜合徵(compensato-ry anti-inflammatory response syndrome, CARS)CARS的作用在於限制炎症,保護機體免受炎症的損害,但可致免疫功能低下,使機體易於感染。
炎症反應的失控與促炎、抗炎效應的失衡有關。一般認為與炎症誘發因素的持續作用以及炎症細胞致敏有關。臨床上感染及休克常誘發SIRS,與細菌、毒素中的持續作用、缺血再灌注損傷使得促炎介質大量生成有關。SIRS也會出現在臨床侵襲經治療情況基本穩定又再次遭遇較輕打擊之後。原發性損傷使機體處於炎症細胞易被激活的“致敏”狀態,而“第二次打擊”即使較輕,也可以造成很強烈的全身反應。
病理生理
微生物普遍地上輩子在於自然界,人體皮膚、黏膜表面和消化道內,但一般並不致病。這是因為人體具有局部和全身防禦功能有損壞或不足,或致病菌數量、毒力過大時,才會發生感染。所以,人體組織接觸致病菌,僅屬污染,並不都發生感染。實驗資料指出,每1g組織內的致病菌數一般需超過106個才引起感染。但局部有壞死組織、血腫或異物等時,抗感染的能力即大為削弱,每1g組織內有100個致病菌即能發生感染。
感染的發生經過:局部組織的損害如各種創傷,甚至肉眼不能察覺到的微小傷口,構成致病菌入侵的門戶。隨著致病菌的侵入,人體即產生防禦反應,在局部出現充血、水腫、壞死等炎症病理變化,全身則出現體溫升高、白細胞計數增加等反應。
在致病菌進入人體組織處發生炎症反應,將致病菌限制於局部。細菌的毒素、細胞和血漿蛋白釋放出來的組織胺、激肽和血管活性物質等的作用,使毛細血管和微靜脈內血流緩慢、壓力增加,並發生擴張,血管通透性和血漿蛋白滲出增加;白細胞粘附在受損的血管內皮細胞上,並從內皮細胞連線處游出至血管外組織。在滲出的血漿蛋白中有抗體、補體等。抗體和細菌表面的抗原相結合,形成抗原抗體複合物,使補體激活,引起一系列的酶反應,釋放趨化因子,改變細菌的表面性質,使它們容易被中性白細胞和大單核細胞所吞噬。在感染的早期,滲出的白細胞以中性白細胞為主,以後大單核細胞逐漸增多。吞噬作用是人體最重要的防禦功能。主要通過血液中的中性白細胞、大單核細胞和分布於肝、脾、肺和淋巴結等器官內的網狀內皮系統來完成。如果吞噬作用能很快將入侵的細菌消滅,則炎症停止發展,組織逐漸修復,可無明顯的臨床感染出現。如果入侵的細菌量大,毒性強,則炎症反應劇烈,出現紅、腫、熱、痛等臨床感染的表現。
在感染灶處,吞噬細胞和調理素的集中,均有賴於血管系統的參與。如果組織灌流減少或炎性反應的發生受到阻止,則吞噬細胞和調理素的釋放均會不足,使人體容易遭受感染。
病程演變
外科感染髮生以年青男子的演變,可以受到下列因素的影響:①致病菌的毒力:因致病菌的種類、菌株、數量、繁殖速度和毒素的性質而定。在混合感染中,細菌之間可以出現協同作用,例如需氧菌的存在用去了傷口的氧,可有助於破傷風桿菌的繁殖。②局部抵抗力:與局部組織結構、血液循環和局部受傷情況有關。頭頸部血液循環豐富,感染易控制,而臀部、腿部大塊肌群損傷,則容易發生氣性壞疽。一般說來,傷口的大小、深淺、有無異物、死腔、血腫和壞死組織等,都與局部抵抗力有密切關係。③全身抵抗力:與年齡、營養、一般情況有關。患有慢性消耗性疾病、貧血、血漿蛋白減少、維生素C嚴重缺乏等,都能消弱全身抵抗力。④及時和正確的治療對控制感染的發展,也起重要的作用。
轉歸
 外科感染---遷延
外科感染---遷延1、局限化、吸收或形成膿腫當人體抵抗力占優勢,感染便局限化,有的自行吸收,有的形成膿腫。而小的膿腫也可自行吸收;較大膿腫在破潰或經手術切開排膿後,轉為修復過程,病變區逐漸長出肉芽組織,形成瘢痕而愈。
2、轉為慢性感染人體抵抗力與致病菌毒力處於相持狀態。感染病灶被局限,形成潰瘍、瘺竇或硬結,由瘢痕纖維組織包圍,不易癒合。病灶內仍有致病菌。在人體抵抗力降低時,感染可以重新急性發作。
3、感染擴散在致病菌的毒力走過人體抵抗力的情況下,感染不能局限,可迅速賂四周擴散或進入淋巴系統、血液循環,引起嚴重的全身性感染。
臨床表現
1、局部症狀紅、腫、熱、痛和功能障礙是化膿性感染的五個典型症狀。但這些症狀不一定全部出現,而隨病程遲早,病變範圍和位置深淺而異。病變範圍小或位置較深的,局部症狀可不明顯。這些症狀的病理基礎就是充血、滲出和壞死三個基本變化。
2、全身症狀輕重不一。感染輕微的可無全身症狀。感染較重的常有發熱、頭痛、全身不適、乏力、食慾減退等,一般均有白細胞計數增加和核左移。病程較長時,因代謝的紊亂,包括水和電解質代謝失調,血漿蛋白減少和肝糖的大量消耗,可出現營養不良、貧血、水腫等。全身性感染嚴重的病人可以發生感染性休克。
診斷
外科感染一般可以根據臨床表現作出正確診斷。波動感是診斷膿腫的主要依據。在淺部膿腫,用示指輕按膿腫一側,同時在水平線的對側,用另一示指稍用壓力或輕輕叩擊,則原來一示指就感到有液體的波動感。在垂直方向再做一次。兩個方向均有波動感者為陽性。深部膿腫,尤其是位於筋膜以下的,波動感不明顯,但膿腫表面組織常有水腫現象,局部有壓痛,全身症狀明顯,可用穿刺幫助診斷。
必要時,還可進行一些輔助檢查,如化驗、超音波、X線檢查和核素檢查等。對疑有全身性感染者應抽血液作細胞培養檢查,但一次陰性結果並不表示不存在全身性感染,應多作幾次細菌培養檢查,以明確診斷。
治療
 外科感染治療---引流
外科感染治療---引流治療外科感染的原則,是消除感染病因和毒性物質(膿液、壞死組織等),增強人體的抗感染和修復能力。較輕或範圍較少小的淺部感染可用外用藥、熱敷和手術等治療;感染較重或範圍較大者,同時內服或注射各種藥物。深部感染一般根據疾病種類作治療。全身性感染更需積極進行全身療法,必要時應作手術。
一、局部療法
1、患部制支、休息可減輕疼痛,而且有利於得炎症局限化和消腫。感染在肢體的,可抬高患肢。必要時,可用夾板或石膏夾板固定。
2、外用藥有改善局部血液循環,散瘀消腫、加速感染局限化,以及促使肉芽生長等作用,大多適用於淺部感染,但有時也用於深部感染。
方法:①新鮮蒲公英、紫花地丁、馬齒莧、敗醬草等搗爛外敷,在淺部感染初期有效。②硫酸鎂溶液濕敷,可用於蜂窩織炎、淋巴結炎等。③金黃散、玉露散、雙柏散等用醋調外敷,適用於淺部或稍深的感染初期或中期。④鯽魚膏、千捶膏等,或魚有脂軟膏,適用於癤等較小的感染中期。⑤已破潰後,可用八二丹、生肌玉紅膏、紅油膏等。
3、物理療法有改善局部血液循環,增加局部抵抗力,促進吸收或局限化的作用,較深的感染,可用熱敷或濕熱敷。耳癤、鼻癤等可用超短波或紅外線。
4、手術治療包括膿腫的切開引流和發炎臟器的切除。膿腫雖穿破但引流不暢者,可行擴大引流術。局部炎症劇烈,迅速擴展,或全身中毒症狀明顯者,亦可切開減壓,引流滲出物,以減輕局部和全身症狀,阻止感染繼續擴展。
二、全身療法 主要用於感染較重,特別是全身性感染的病人,包括支持療法和抗菌藥物等。
1、支持療法目的是改善病人全身情況和增加抵抗力,使各種療法可以通過人體防禦功能而發揮作用。
(1)保證病人有充分的休息和睡眠,必要時用鎮靜、止痛藥物。
(2)高熱量和易消化的飲食,補充多種維生素,尤其是維生素B、C。
(3)高熱病人,宜用物理降溫法(冷敷、冰袋、酒精擦浴)或針刺曲池穴降溫,以減少身體的深消耗。
(4)高熱和不能進食的病人,應經靜脈輸液,補充所需的液化格熱量,並糾正水、電解質代謝和酸鹼平衡失調。
(5)有貧血、低蛋白血症或全身性消耗者,應予輸血。特別是敗血症時,多次適量的輸入鮮血,可補充抗體、補體和白細胞等,對增強抵抗力、恢復體質有很大幫助。
(6)有條件時,嚴重感染的病人可給予胎盤球蛋白、丙種球蛋白或康復期血清肌肉注射,以增加免疫能力。
(7)對嚴重感染,可考慮套用腎上腺皮質激素,以改善病人的一般情況,減輕中毒症狀。但腎上腺皮質激素有使感染擴散的危險,並能掩蓋臨床症狀,使用時必須同時給予足量有效的抗生素並進行嚴密觀察。
2、抗菌藥物套用這類抗菌藥物必須有一定的適應證。對較輕或較局限的感染,一般可不用抗菌藥物。對較重、範圍產大或有擴展真摯的感染,才需全身用藥。通常可根據各種致病菌引起感激的一般規律(如癰主要由金黃色葡萄球菌引起,丹毒由鏈球菌引起)、臨床表現、膿液性狀、感染來源等,對致病菌種類作出初步判斷,選擇藥物。如果2~3日後療效仍不明顯,則應更換藥物種類。如能作細菌培養和敏感試驗,則更可作為選用藥物的指導。
3、中藥 一般可用清熱解毒的蒲公英、紫花地丁、野菊花、金銀花等煎劑,或用銀黃片、清熱消炎片、解毒消炎丸等成藥。對較嚴重的感染應辯證論治。
預防
總的原則是增強人體的的全身和局部抵抗力,減少致病菌進入人體的機會。
1、開展衛生宣傳,注意個人衛生,及時治療各種瘙癢性皮膚病,以防止體表化膿性感染的發生。
2、做好勞動保護工作,預防創傷的發生;及時和正確處理,包括做好清創術。
3、糖尿病、尿毒症、白血病、大劑量激素療法和抗癌療法等均可消弱人體護御感染的能力。要加強對這些病人的醫療和護理,以防嚴重感染的發生。
4、注意手術時的無菌技術,操作輕柔,愛護組織,徹底止血,防止積液。
5、換藥、氣管切開、靜脈內插管、留置導尿管,以及燒傷病人的護理,均應遵守無菌操作規則,以預防或減少感染的發生。
6、套用免疫療法,如破傷風類毒素或抗毒素預防破傷風。
7、合理使用預防性抗菌藥物。
護理
 外科感染病人護理
外科感染病人護理外科感染病種分類較多,在施行護理工作中既有共性又有特性.因此,我們在護理各種疾病時,必須因症鏇護,這樣才能獲得理想的康復效果。
一、共性護理:
1、保護皮膚。防止皮膚破損,遇蟲叮蚊咬後切忌以指甲抓癢,避免抓破皮膚而引起感染,可使用清涼油或止痛癢噴霧劑,以解痛癢,保持皮膚清潔乾燥,每日以優質肥皂擦洗乾淨,暑天大量分泌汗液時,不宜在臉面部搽油抹粉,以免阻塞毛孔引起炎症,但某些部位,如臀部、腋下、腹股溝等易摩擦處,可施工以少量滑石數,使之滑潤乾燥,避免擦破。
2、熱敷與抬高患肢。一般感染初期均會出現紅腫硬塊,熱敷可使炎症消散或局限促其成熟,濕熱敷溫度約50~60℃,用二塊 不布墊,交替使用,熱敷之前,局部皮膚搽以凡士林,上面再覆蓋紗布以保護皮膚.乾熱敷即用熱水袋,溫度約60~70℃,熱水袋加套,防止燙傷。感染肢體要抬高,上肢以繃帶從頸項懸下吊起肢體,高於或平心臟位,承重受壓部位以棉墊襯墊;下肢用枕頭或海綿塊,墊高30℃左右,以利血液和淋巴液回流,減少腫脹。
3、傷口引流護理。一旦膿腫形成,即應切開排膿,若是非曲直較小癤子,可用消毒針頭刺破,排出膿液,外敷消炎藥膏即可。但臉面、上唇周圍、鼻部俗稱危險三角區生癤,不宜護壓,以防細菌沿內眥靜脈和眼靜脈進入頻內的海綿竇,而引起顱內感染,頗為危險。較大的癤則需切開排膿,癰和蜂竄組織炎,病變範圍較廣,一般作多處切開,病變較深者,應放引流條。每日以生理鹽水或1:1000協佛媽爾清洗傷口及更換敷料,必要時每日2次,嚴格執行無菌操作。
4、支持護理;即全身性支持療法的護理。
A 思想引導:使病人對疾病的康復有充分信心,積極配合醫療與護理,有樂觀的情緒。
B 營養補充:病人表現食欲不振或厭食,在保證營養供給的情況下,經常調換品種、烹調色、香、味美的食物以誘增欲。病情嚴重不能口服者,應從靜脈輸液輸血,保證每天有2000千卡熱量供給。保護輸液管道通暢,根據病情需要維持應有的滴速是至關重要的。
C 高熱護理:嚴重感染者均會出現高燒,要勸說病人多飲開水或飲料,給機體補充水分和沖淡毒素。體溫高至39℃以上時,給以物理降溫。大汗淋漓時,以溫水揩洗皮膚,及時更換汗濕的衣褲與床單。
D 病情觀察:注意局部傷口的轉歸,以及全身生命體徵的變化,認真填寫護理記錄單,提供可靠的診療根據。危重病人呼吸困難者,要及時供氧,有呼吸道陰塞現象,應即用吸痰等措施排除阻塞,同時報告醫生並準備好氣管切開用物。
E 重社口腔與皮膚清潔:防止褥瘡。
二、特殊護理:
1、隔離消毒措施:
A 丹毒及綠膿桿菌感染者,應做好床邊隔離;個人用物隔離,特別是換藥器械,用後需單旬浸泡消毒,貼近傷口之敷料要焚毀,其餘敷料亦應單獨處理。
B 破傷風及氣性壞疽病人,應嚴格隔離;病人住單人病室,專人護理,控制出入人員;護理病人要穿隔離衣、戴帽子、口罩,室內紫外線照射每日2次,地面用2%次氯酸鈉拖洗,每日1~2次;病人用過的敷料應一律焚毀;器械先用碘伏(300ppm含量)浸泡20分鐘,清洗後再行高壓滅菌並採取間隙消毒滅菌法,即按正常高壓滅菌,每日1次,進行3次消毒。可殺死所有芽孢。
2、破傷風特殊護理:
A 環境要安靜,避免噪音,室內無強光照射,工作人員走路、說話、開關門窗等動作要輕,因任何刺激均會引起病人劇烈的肌肉痙攣,所以護理工作要有計畫性,治療與擴理能在一次接角病人時完成為好,這樣可減少翻動和刺激病人。如能解痙、鎮靜藥的配合下進行更好。
B 抽搐痙攣時,防止墜床。口內置牙墊或墊紗布,防止舌唇咬破。記錄抽搐時間和程度。呼吸肌痙攣有窒息情況時,及時準備氣管切開用物。
C 破傷同抗毒素(T.A.T.):是從動物血清中提煉的異性蛋白,可導致過敏。因此,注射前要做皮試,方法:取0.1ml抗毒素以生理鹽水稀釋至1ml,在前臂內側腕關節上5~8cm 處,注入0.1ml稀釋液於皮內作一皮丘.觀察20分鐘,局部無反應為陰性,創傷後預防破傷風時,可將T.A.T.1500u一次性肌注。如皮試局部出現紅暈大於皮丘或皮丘周圍有紅色偽足,均為陽性,應採取脫敏注射。脫敏注射方法:將T.A.T.1500u,稀釋成5ml,觀察20分鐘,無任何不適者,第二次肌注2ml,觀察同上,仍無不適,第三次最後劑量注入,再觀察30分鐘後,才能讓病人離去。在脫敏注射時應備有1:1000鹽酸腎上腺素1ml,以便函發生過敏反應時,緊急注射。破傷風發病時的治療劑量較大,每日用量在1萬u以上。
3、高壓氧治療氣性壞疽護理:
A 嚴格執行隔離制度,創面以消毒巾遮蓋,各種用物備齊;
B 入艙前排空大小便;
C 病人忌穿尼龍類化纖織物衣褲進艙;
D 加壓時,鼓膜內陷脹痛,囑病人扭鼻鼓氣、咀嚼或作吞咽動作,同時艙溫上升,給病人適當寬衣,有引流管者要夾緊,防止高壓返流。
E 減壓時,溫度下降注意保暖,及開放引流管。
4、厭氧菌感染的傷口護理:要徹底清除創內壞死組織,暴露死腔,用3%過氧化氫或0.5%~0.1%高錳酸鉀溶液沖洗傷口,亦可濕敷創面,以對抗厭氧菌的生長,沾污敷料一律以廢紙包裹送去焚燒,器械浸泡於指定消毒桶內。工作人員要嚴格消毒雙手,防止交叉感染.
相關內容
一、常見病原菌的耐藥現狀
細菌耐藥與濫用抗生素關係極大。據統計一般國家住院病人約有30%使用抗生素,美國為20%,而我國為67%~80%,從而帶來嚴重的耐藥問題,尤其在大城市、大醫院。據北京、上海、武漢等地的大醫院資料,金黃色葡萄球菌和凝固酶陰性葡萄球菌的耐藥率,對青黴素和氨苄西林高達84%~94%,對哌拉西林也有45%~73%,對氨苄西林/舒巴坦、頭孢唑啉和阿米卡星只有0.3%~2%,對亞胺培南為0~0.7%,對萬古黴素為0。甲氧西林耐藥葡萄球菌(MRSA和MRSE)半數以上對絕大多數抗生素耐藥,對亞胺培南耐藥者也有10%~56%,只有對萬古黴素仍100%敏感。腸球菌24%~29%對青黴素類耐藥,對頭孢菌素類耐藥率更高,對慶大黴素92%耐藥;對萬古黴素耐藥者雖然只有2%~3.5%,但這些耐萬古菌株(主要是屎腸球菌)幾乎對所有其它抗菌藥耐藥,處理上極為棘手。在G-桿菌中,大腸桿菌和克雷伯菌屬對氨苄西林的耐藥率為80%~95%,對哌拉西林為28%~53%,對慶大黴素為29%~42%,對環丙沙星分別為44%~60%和8.2%~22%,對頭孢他啶為2%~12%,對其它第三代頭孢菌素為11.5%~27%,對亞胺培南為0~2%,對阿米卡星為2.9%~17%;腸桿菌屬和不動桿菌的耐藥性還要高得多,據武漢最新調查,他們對氨苄西林和第一、二代頭孢菌素的耐藥率已達到或接近100%;綠膿桿菌對哌拉西林的耐藥率為20%~22%,對頭孢哌酮為16%~19.5%,對頭孢他啶為2%~11.2%,對亞胺培南為4%~14%,對慶大黴素為46%~56%,對阿米卡星為10%~11.1%,對環丙沙星為5%~31%。令人不安的是,細菌對抗生素的耐藥率仍在持續增長。
二、診斷進展
根據病史、症狀和體徵和白細胞計數和分類進行綜合判斷,仍然是感染的基本診斷方法。細菌檢測陽性是診斷感染的過硬指標,但經典的培養方法卻不夠敏感,而且不能檢出已被吞噬或殺滅的細菌,培養所需的時間也太長。為了提高培養陽性率和儘快得到結果,可採用選擇性培養基,改善培養條件,或使用微生物快速自動診斷儀。更精確的方法是利用PCR技術擴增血中或組織中細菌共有或某種細菌特有的DNA片段進行檢測,既有很高的敏感度,又有很高的特異性。隨著外科和創傷感染概念的拓寬,人們的視野不再局限於有明確感染灶的感染,而是越來越多地注意到表現為全身炎症反應、卻不伴有感染灶的。腸源性感染來源於黏膜屏障損害引起的腸道細菌易位,但在臨床上很難診斷,PCR技術的套用對發現和證實腸道細菌易位有著重要價值。人們一直企圖尋找出某些能夠鑑別有無感染及反映感染嚴重程度的簡單指標,已研究過的有C-反應蛋白、白介素-6、降鈣素前肽procalcitonin等,但結果都使人失望,前景也不看好。
三、預防的進展
改進、加強圍手術期處理能從多方面降低手術感染的風險。業已證明手術前一天進行手術區皮膚剃毛的傳統方法是術後傷口感染的危險因素,在手術開始前即時剃毛或在毛髮稀疏部位不剃毛能明顯減少傷口感染。操作技巧也與術後感染有密切關係。解放軍304醫院曾調查了9500例手術後感染情況,發現腦外科病人感染率最高,達9.37%,4名主刀者的術後感染專率差異很大(1.3%~22.9%),經有針對性地改進操作技巧,局面得到了改觀。
抗生素對術後感染的預防價值不容置疑,但實際套用常有不當,主要是(1)用藥過晚。(2)套用時間過長。(3)選藥不當。因此應強調如下原則:(1)在手術即將開始前靜脈用藥,若手術結束回病房後再用藥,已錯過時機,與不用藥無何區別。(2)有針對性選用廣譜殺菌劑。頭頸、四肢手術,選用主要針對G+球菌的抗生素如頭孢唑林、頭孢拉定;胸、腹腔手術,選用主要針對G-桿菌的抗生素如廣譜青黴素或第二、三代頭孢菌素;涉及食管、大腸和女性生殖器官的手術,選用同時有抗厭氧菌活性的抗生素或抗生素與抗厭氧菌藥物(如甲硝唑)聯用。(3)套用時間要短,基本上是一次性用藥,手術後繼續用藥數天並不能進一步降低感染髮生率。這些行之有效的做法已被國內外大量前瞻性對比研究所肯定,但在普遍推廣方面還有大量工作要做。
局部套用抗生素的主要進展是開發了慶大黴素-PMMA骨水泥和慶大黴素-PMMA明膠海棉為代表的抗生素緩釋系統,改變了過去傷口局部撒布或灌注抗生素效果不佳甚至引起不良反應的現象,展示了較好的套用前景。
四、治療的進展
外科感染治療的進展之一,是研究者們在充分重視抗菌藥物治療和必要時手術干預(引流等)的同時,從更廣闊的視角看待感染,力圖從改善機體狀況著手迎接感染的挑戰。例如以“免疫調理”的手段降低感染的易感性,以“代謝調理”的手段(如使用環氧酶抑制劑減輕發熱和炎症)抑制分解代謝,套用生長激素促進蛋白質合成,增強機體對感染的防禦能力,加強維護腸道屏障的措施以控制腸道內毒素和細菌易位等,國內都已在臨床上開始了有益的嘗試,雖然離成熟還相距甚遠,卻很可能是一條有希望的出路。
微創技術的發展也為抗感染治療增添了新的手段。經內鏡置入鼻膽管,內鏡下行Oddi括約肌切開,經皮經肝膽道置管或安放支架,都能立即緩解梗阻性膽道感染,使病人得以渡過難關,以便爾後在較好狀態下接受決定性手術治療。B超或CT引導下穿刺置管引流,使許多膈下膿腫等深在化膿性病灶病人免於手術。
抗菌藥物治療的進步,與其說在於新藥的開發,不如說在於強調藥物的合理套用。要做到合理用藥,必須認真掌握不同種類和具體藥物的抗菌譜及藥效動力學和藥代動力學特徵,掌握感染病原學包括細菌對抗菌藥物的耐藥狀況,結合病人的具體情況,審時度勢,精心選藥、配伍,並制定合理的用藥方案。要十分重視病原學調查,儘快以針對性用藥取代治療初期的經驗性用藥。能用窄譜藥者,不要濫用廣譜藥。對危重感染,則要選用能有效控制(覆蓋)外科感染最常見的細菌(G-腸道桿菌、G+球菌和綠膿桿菌)的藥物或藥組,這就是“全面覆蓋”的方針。所用藥物對細菌的覆蓋率越高,治療成功的可能性就越大。根據近年多項調查,對細菌覆蓋率最高的幾種抗菌藥是亞胺培南、頭孢他啶、阿米卡星、哌拉西林/他唑巴坦、環丙沙星和其它第三代頭孢菌素。
